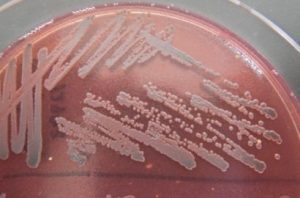

豚のスス病の症状と治療法
豚のスス病って何?
ススを被ったような病変からスス病と俗称される、正式名称は滲出性皮膚炎
(exudative epidermitis)という疾病です。生産現場において重大な経済的損失をもたらすこの疾病は日本でも散発的に発生がみられ、特に乳離れ前後の仔豚に発生が多いとされています。初期であれば治療により回復しますが、慢性化すると一般的に予後不良又は死亡することもり、基本的な飼育環境の改善と衛生管理の徹底、早期発見、早期治療が求められる疾病といえます。
この疾病の病因とは?
この疾患の主な原因菌はブドウ球菌の仲間、Staphylococcus hyicus(以下S.hyicus)によって引き起こされる皮膚炎が特徴です。S.hyicus(写真1)はグラム陽性の球菌で、皮膚の常在菌として広く存在しており、特定の条件下で病原性を示します。この菌は、表皮剥離毒素(exfoliative toxin)を産生し、これが角質層間の接着を破壊することで皮膚のバリア機能が損なわれ、その結果、滲出性皮膚炎の特徴である膿疱、びらん、および皮膚の肥厚が生じます。
写真1◆S.hyicus(卵黄加マンニット食塩寒天培地※亜テルル酸カリウム含有)
※S.hyicusはマンニット非分解
主な発症要因
発症には複数の要因が関与します。特に離乳後の子豚は母豚からの移行抗体が切れると同時に多くのストレスがかかる時期である為病気に一番罹患しやすい期間です。以下のような要因が発症のリスクにつながりますが、これらの管理を徹底することで発症のリスクは下げることができます。
臨床症状と診断
臨床的には、被毛の剥落、皮膚の紅斑、びらん、痂皮形成などが観察されます。病変は主に顔、耳、腹部に多く見られ、重症例では全身に広がることがあります。診断は、臨床症状の観察に加え、皮膚病変からの細菌培養と感受性試験が行われます。
また、診断には疥癬、豚痘、シラミなど他の皮膚炎との類症鑑別を要します。
治療と管理
治療には抗生物質の投与が主に用いられますが、S. hyicusは多剤耐性を示すことがあり、感受性試験に基づく適切な抗生物質の選択が重要となります。局所療法として、消毒薬や抗生物質含有軟膏の塗布も有効です。また、病変部の乾燥を保つことも推奨されます。
予防策
予防には、飼育環境の改善と衛生管理の徹底が不可欠です。適切な飼育密度の維持、飼育設備の定期的な清掃と消毒、栄養バランスの取れた飼料の供給などが含まれます。特に、湿潤環境の回避と外傷の予防が重要です。また、ストレス軽減策として、適切な温度管理や十分な休息環境の提供も必要とされます。
最後に
梅雨に入り、雑菌が繁殖しやすい季節となりました。豚スス病は換気の不足する時期に多く見られますが、衛生管理の面でこれからの季節に向けた基本的な飼育管理を重要とする疾病、豚スス病について今回とりあげました。株式会社食環境衛生研究所では豚のスス病に関する検査を行っております。この疾病、又は類似の症状がみられた際は弊社での検査をお待ちしております。
>>スス病検査ページはこちら
>>豚/病性鑑定・微生物検査ページはこちら
>>お問い合わせはこちら